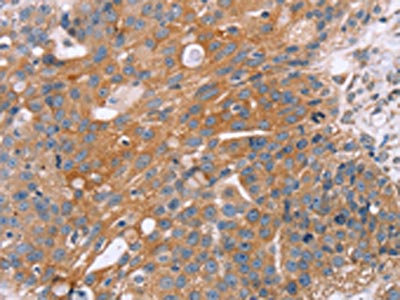

-
中文名稱:OPTN兔多克隆抗體
-
貨號:CSB-PA548038
-
規格:¥1100
-
圖片:
-
The image on the left is immunohistochemistry of paraffin-embedded Human breast cancer tissue using CSB-PA548038(OPTN Antibody) at dilution 1/25, on the right is treated with fusion protein. (Original magnification: ×200)
-
The image on the left is immunohistochemistry of paraffin-embedded Human esophagus cancer tissue using CSB-PA548038(OPTN Antibody) at dilution 1/25, on the right is treated with fusion protein. (Original magnification: ×200)
-
-
其他:
產品詳情
-
Uniprot No.:
-
基因名:
-
別名:14.7K interacting protein antibody; Ag9 C5 antibody; ALS12 antibody; E3 14.7K interacting protein antibody; E3-14.7K-interacting protein antibody; FIP 2 antibody; FIP-2 antibody; FIP2 antibody; Glaucoma 1 open angle E (adult onset) antibody; Glaucoma 1 open angle E antibody; GLC1E antibody; HIP 7 antibody; HIP-7 antibody; HIP7 antibody; Huntingtin interacting protein 7 antibody; Huntingtin interacting protein HYPL antibody; Huntingtin interacting protein L antibody; Huntingtin yeast partner L antibody; Huntingtin-interacting protein 7 antibody; Huntingtin-interacting protein L antibody; HYPL antibody; Injury inducible protein I 55 antibody; NEMO related protein antibody; NEMO-related protein antibody; NRP antibody; Optic neuropathy inducing protein antibody; Optic neuropathy-inducing protein antibody; Optineurin antibody; OPTN antibody; OPTN_HUMAN antibody; TFIIIA IntP antibody; TFIIIA-IntP antibody; Transcription factor IIIA interacting protein antibody; Transcription factor IIIA-interacting protein antibody; Tumor necrosis factor alpha inducible cellular protein containing leucine zipper domains antibody
-
宿主:Rabbit
-
反應種屬:Human,Mouse,Rat
-
免疫原:Fusion protein of Human OPTN
-
免疫原種屬:Homo sapiens (Human)
-
標記方式:Non-conjugated
-
抗體亞型:IgG
-
純化方式:Antigen affinity purification
-
濃度:It differs from different batches. Please contact us to confirm it.
-
保存緩沖液:-20°C, pH7.4 PBS, 0.05% NaN3, 40% Glycerol
-
產品提供形式:Liquid
-
應用范圍:ELISA,IHC
-
推薦稀釋比:
Application Recommended Dilution ELISA 1:1000-1:2000 IHC 1:25-1:100 -
Protocols:
-
儲存條件:Upon receipt, store at -20°C or -80°C. Avoid repeated freeze.
-
貨期:Basically, we can dispatch the products out in 1-3 working days after receiving your orders. Delivery time maybe differs from different purchasing way or location, please kindly consult your local distributors for specific delivery time.
-
用途:For Research Use Only. Not for use in diagnostic or therapeutic procedures.
相關產品
靶點詳情
-
功能:Plays an important role in the maintenance of the Golgi complex, in membrane trafficking, in exocytosis, through its interaction with myosin VI and Rab8. Links myosin VI to the Golgi complex and plays an important role in Golgi ribbon formation. Plays a role in the activation of innate immune response during viral infection. Mechanistically, recruits TBK1 at the Golgi apparatus, promoting its trans-phosphorylation after RLR or TLR3 stimulation. In turn, activated TBK1 phosphorylates its downstream partner IRF3 to produce IFN-beta. Plays a neuroprotective role in the eye and optic nerve. May act by regulating membrane trafficking and cellular morphogenesis via a complex that contains Rab8 and hungtingtin (HD). Mediates the interaction of Rab8 with the probable GTPase-activating protein TBC1D17 during Rab8-mediated endocytic trafficking, such as of transferrin receptor (TFRC/TfR); regulates Rab8 recruitment to tubules emanating from the endocytic recycling compartment. Autophagy receptor that interacts directly with both the cargo to become degraded and an autophagy modifier of the MAP1 LC3 family; targets ubiquitin-coated bacteria (xenophagy), such as cytoplasmic Salmonella enterica, and appears to function in the same pathway as SQSTM1 and CALCOCO2/NDP52.; (Microbial infection) May constitute a cellular target for adenovirus E3 14.7 and Bluetongue virus protein NS3 to inhibit innate immune response.
-
基因功能參考文獻:
- rs1561570 may contribute to Paget's disease of bone since its T allele results in the loss of a methylation site in patients' DNA, leading to higher levels of OPTN gene expression and a corresponding increase in protein levels in patients' osteoclasts. PMID: 29782529
- Results suggest that Optn potentiates LC3-II production and maturation of the phagophore into the autophagosome, by facilitating the recruitment of the Atg12-5-16L1 complex to Wipi2-positive phagophores. PMID: 29133525
- Immunohistochemical analyses of motor neurons from OPTN-associated amyotrophic lateral sclerosis patients reveal that linear ubiquitin and activated NF-kappaB are partially co-localized with cytoplasmic inclusions, and that activation of caspases is elevated. PMID: 27552911
- This study describes the crystal structures of optineurin/TBK1 complex and the related NAP1/TBK1 complex, uncovering the detailed molecular mechanism governing the optineurin and TBK1 interaction, and revealing a general binding mode between TBK1 and its associated adaptor proteins. PMID: 27620379
- Data suggest that OPTN mRNA and protein expression are significantly decreased in fetal membranes and myometrium during spontaneous term labor; there appears to be no effect of preterm labor on OPTN expression in fetal membranes. In cultured myometrial cells, RNA interference of OPTN up-regulates expression of inflammation mediators in response to IL1B (inteleukin-1B). PMID: 27133964
- When yeast genetic interaction partners held in common between human OPTN and ANG were validated in mammalian cells and zebrafish, MAP2K5 kinase emerged as a potential drug target for amyotrophic lateral sclerosis therapy PMID: 28596290
- A new variant associated with Paget's Disease of Bone in OPTN, reinforcing the relevance of this gene for the development of this bone disease. PMID: 28993189
- OPTN colocalizes with LC3 (autophagic vesicle marker) and alpha-synuclein positive puncta in rotenone-treated animals, potentially indicating an important role in autophagy and PD pathogenesis PMID: 27473339
- Given the critical roles of TBK1, important regulatory mechanisms are required to regulate its activity. Among these, Optineurin (Optn) was shown to negatively regulate the interferon response, in addition to its important role in membrane trafficking, protein secretion, autophagy and cell division. PMID: 26976762
- E50K, M98K, Q398X and E478G mutations in OPTN affect neuronal viability under normal or oxidative stress conditions. PMID: 26956627
- We report a five-generation pedigree with a complex pattern of primary open angle glaucoma(POAG) inheritance; familial clustering of POAG in this pedigree is consistent with dominant inheritance of a glaucoma-causing gene, mutations were not detected in genes previously associated with autosomal dominant glaucoma, suggesting the involvement of a novel disease-causing gene in this pedigree. PMID: 27355837
- These results suggest that the IRAK1-binding protein OPTN negatively regulates IL-1beta/LPS-induced NF-kappaB activation by preventing polyubiquitination of TRAF6. PMID: 28882891
- This study therefore provides novel information regarding the role of Optn during T-cell activation, suggesting the possible importance of Optn during inflammation and/or autoimmune diseases. PMID: 28192730
- Frontotemporal dementia -linked mutations in gene OPTN encoding autophagy adaptor proteins , indicate that impaired autophagy might cause Frontotemporal dementia. PMID: 27166223
- The present study provides insight into the genetic or haplotype variants of MYOC and OPTN genes contributing to primary glaucoma. Haplotype variants identified in the present study may be regarded as potential contributing factors of primary glaucoma in Korea. PMID: 27485216
- the E50K OPTN mutation markedly reduced the levels of miR-9, which led to alterations in REST and reduced expression levels of BDNF in RGC-5 cells. PMID: 27748809
- ALS-linked mutations in OPTN and TBK1 can interfere with mitophagy, suggesting that inefficient turnover of damaged mitochondria may represent a key pathophysiological mechanism contributing to neurodegenerative disease. PMID: 27247382
- We conclude that OPTN mutations are associated with Amyotrophic lateral sclerosis PMID: 26303227
- In combination with phosphorylation of S177 and S513, this posttranslational modification promotes recruitment and retention of OPTN/TBK1 on ubiquitinated, damaged mitochondria PMID: 27035970
- Familial linkage studies for primary angle-closure glaucoma have been performed and identified OPTN causative primary angle-closure glaucoma disease PMID: 26497787
- Nine OPTN variants were identified in Chinese sporadic ALS patients, including 5 known SNPs and four novel missense mutations: c.407C > T (p.A136V), c.1184A > G (p.K395R), c.1352T > C (p.I451T), and c.1546G > C (p.E516Q) (all heterozygous). PMID: 26503823
- OPTN 691_692insAG is a founder mutation in Moroccan and Ashkenazi Jews with ALS. PMID: 26740678
- A polymorphism of optineurin, M98K, associated with glaucoma, causes enhanced autophagy leading to transferrin receptor degradation and apoptotic death of retinal cells. PMID: 26302410
- Optineurin can also mediate the removal of protein aggregates through an ubiquitin-independent mechanism. This protein in addition can induce autophagy upon overexpression or mutation. PMID: 26142952
- Optineurin binding to myosin VI was also decreased in tissue lysates from sporadic amyotrophic lateral sclerosis spinal cords. PMID: 25859013
- Optineurin mediates its functions by interacting with various proteins and disease-causing mutations alter these interactions leading to functional defects in membrane vesicle trafficking, autophagy, signaling. PMID: 25855473
- Data suggest OPTN is involved in upregulation of innate immunity in mitosis; mechanism involves phosphorylation/mitochondrial translocation of TBK1 (NF-kB-activating kinase) and phosphorylation/nuclear translocation of CYLD (cylindromatosis protein). PMID: 25923723
- Loss-of-function variants in OPTN and TBK1 are associated with clinical and pathological frontotemporal dementia without motor neuron disease; TBK1 mutations are common cause of frontotemporal lobar degeneration with TAR DNA-binding protein 43 inclusions PMID: 25943890
- that ubiquitin (Ub)-binding domain mutants compromise the maturation of autophagosomes, which in turn interfered with optineurin-mediated autophagy and clearance of inclusion bodies PMID: 25484089
- optineurin is recruited to ubiquitinated mitochondria downstream of PARK2, and induces autophagosome assembly around mitochondria PMID: 25801386
- ALS-linked mutations in both OPTN and UBQLN2 interfere with the constitution of specific endosomal vesicles, suggesting that the vesicles are involved in protein homeostasis and that these proteins function in common pathological processes. PMID: 25398946
- two receptors previously linked to xenophagy, NDP52 and optineurin, are the primary receptors for PINK1- and parkin-mediated mitophagy PMID: 26266977
- optineurin appears to play an important role in the maintenance of the podocyte Golgi complex. PMID: 25096716
- Loss of optineurin in vivo results in elevated cell death and alters axonal trafficking dynamics PMID: 25329564
- optineurin is an autophagy receptor in parkin-mediated mitophagy; defects in a single pathway can lead to neurodegenerative diseases with distinct pathologies PMID: 25294927
- According to molecular genetic studies, OPTN causative gene involved in the development of Primary open-angle glaucoma. PMID: 25711070
- under-expressed in subgroups of CD patients. The most common of these was optineurin (OPTN) which was under-expressed in approximately 10% of the CD patients. PMID: 24943399
- that the loss-of-function, but not the proteinopathy itself, of OPTN leads to multisystem neurodegeneration. PMID: 23889540
- HACE1-OPTN axis synergistically suppresses growth and tumorigenicity of lung cancer cells. PMID: 25026213
- Three mutations of OPTN were identified in Japanese Amyotrophic lateral sclerosis patients PMID: 24085347
- the crystal structure of Rab25 in complex with the C-terminal region of FIP2, which consists of a central dimeric FIP2 coiled-coil that mediates a heterotetrameric Rab25-(FIP2)2-Rab25 complex. PMID: 24056041
- NMR and crystal structures of the autophagy modifier LC3B in complex with the LC3 interaction region of optineurin. PMID: 23805866
- OPTN in cooperation with TDP-43 might be involved in the pathophysiological mechanisms of skeletal muscular degeneration in myopathy PMID: 22860700
- Identification of a functional IRF-1-binding site in the first intron of human optineurin gene that mediates interferon-gamma-induced activation of the promoter, is reported. PMID: 23811275
- Knockdown of Rab12 increased transferrin receptor level and reduced M98K-induced cell death. PMID: 23357852
- Detection of a novel truncating OPTN mutation associated with an aggressive form of amyotrophic lateral sclerosis (ALS) and confirmation that OPTN mutations are a rare cause of ALS. PMID: 23062601
- Progressive aphasia as the presenting symptom in a patient with amyotrophic lateral sclerosis with a novel mutation in the OPTN gene. PMID: 23282279
- Optineurin acts as an adaptor to bring together Rab8 and its GTPase-activating protein TBC1D17. PMID: 22854040
- The results of this study concluded that OPTN mutations associated with ALS are rare in British ALS patients. PMID: 22892313
- This study suggests that mutations in OPTN are not the main cause of ALS in the Japanese population. PMID: 22708870
顯示更多
收起更多
-
相關疾病:Glaucoma 1, open angle, E (GLC1E); Glaucoma, normal pressure (NPG); Amyotrophic lateral sclerosis 12 (ALS12)
-
亞細胞定位:Cytoplasm, perinuclear region. Golgi apparatus. Golgi apparatus, trans-Golgi network. Cytoplasmic vesicle, autophagosome. Cytoplasmic vesicle. Recycling endosome.
-
組織特異性:Present in aqueous humor of the eye (at protein level). Highly expressed in trabecular meshwork. Expressed nonpigmented ciliary epithelium, retina, brain, adrenal cortex, fetus, lymphocyte, fibroblast, skeletal muscle, heart, liver, brain and placenta.
-
數據庫鏈接:
Most popular with customers
-
-
YWHAB Recombinant Monoclonal Antibody
Applications: ELISA, WB, IHC, IF, FC
Species Reactivity: Human, Mouse, Rat
-
Phospho-YAP1 (S127) Recombinant Monoclonal Antibody
Applications: ELISA, WB, IHC
Species Reactivity: Human
-
-
-
-
-